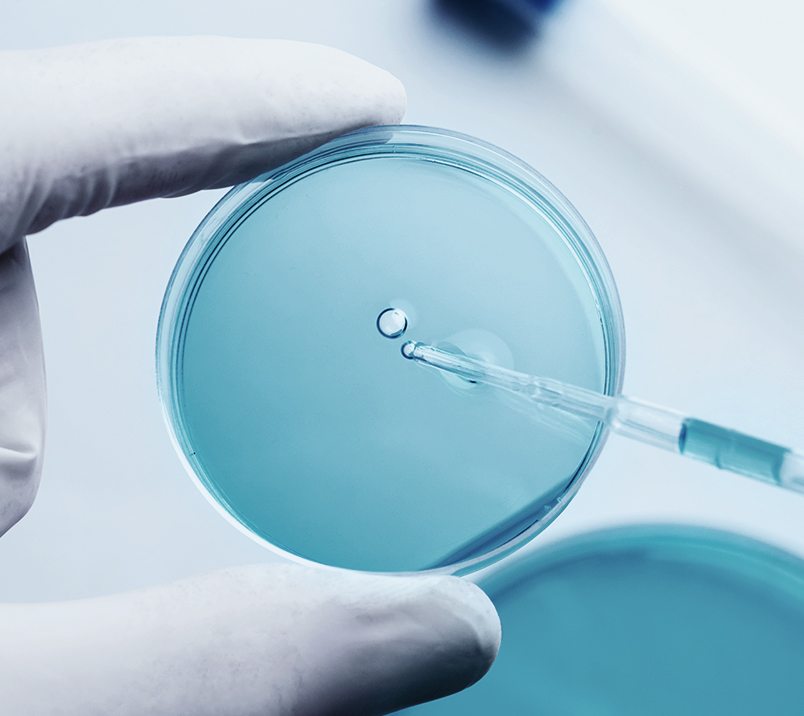

Pure, Potent, Proven.

Explore Our Range of Research-Grade Peptides
Synergetics provides high-purity peptides tailored for researchers and innovators across the UK. Our product selection is sourced from reputable manufacturers and undergoes rigorous quality control to ensure consistency, purity, and reliability.
We are committed to transparency, regulatory compliance, and scientific integrity.
With fast UK shipping and responsive customer support, we’re here to help streamline your research and support your next breakthrough.
Explore our catalogue now.
Product Listings
-
Regular price £75.00Regular priceUnit price / per
-
Regular price £60.00Regular priceUnit price / per







